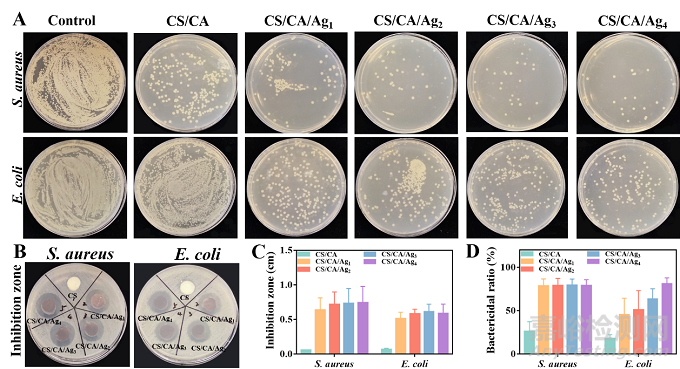

皮膚是人體最大且最容易受到外界傷害的器官。在遭受損傷后其抵御細(xì)菌侵害及維持體液的功能降低。傷口敷料一般可以完成止血,并在皮膚損傷后提供暫時(shí)的保護(hù)。然而,傳統(tǒng)的傷口敷料(如紗布和繃帶)雖然具有一定作用,但是大部分只具備單一止血的功能同時(shí)生物降解性差,并且缺乏預(yù)防細(xì)菌感染和促進(jìn)組織再生的作用。在創(chuàng)面恢復(fù)過程中,創(chuàng)面敷料良好的降解性和抗菌性能起到促進(jìn)作用。因此,開發(fā)低成本且同時(shí)滿足止血、抗感染和促進(jìn)傷口修復(fù)等需求的傷口敷料是有意義的。
近期,山東大學(xué)陳景帝教授團(tuán)隊(duì)通過簡單物理交聯(lián)制備了一種具有止血和皮膚傷口修復(fù)功能的形狀記憶和抗菌殼聚糖冷凍凝膠。在本研究中,在-20℃條件下,隨著水的結(jié)晶,CA和CS的局部濃度增加,CS的NH3+和CA的COO-在靜電吸引作用下緊密交聯(lián)形成CS/CA冷凍凝膠。為增強(qiáng)殼聚糖冷凍凝膠的抗菌性,以單寧酸(TA)為還原劑,將銀納米粒子(Ag NPs)引入到冷凍凝膠中。CS/CA/Ag冷凍凝膠具有良好的力學(xué)性能和相互連通的大孔結(jié)構(gòu)。止血試驗(yàn)結(jié)果表明,CS/CA/Ag冷凍凝膠較商用明膠海綿和紗布能吸收大量血液,促進(jìn)血細(xì)胞粘附。同時(shí),CS/CA/A冷凍凝膠對(duì)金黃色葡萄球菌和大腸桿菌具有良好的抗菌能力。此外,CS/CA/Ag冷凍凝膠顯著促進(jìn)金黃色葡萄球菌感染全層創(chuàng)面模型的創(chuàng)面愈合。綜上所述,用簡單方法制備的低溫凝膠在快速止血和促進(jìn)創(chuàng)面愈合方面具有很大的優(yōu)勢(shì)。
圖1 A) CS與CA之間形成冷凍凝膠的機(jī)理;B) CS/CA/Ag冷凍凝膠形成機(jī)理。
圖2 CS/CA/Ag冷凍凝膠的抗菌性能。A) 金黃色葡萄球菌、大腸桿菌培養(yǎng)板代表性展示圖;B) 抑菌圈代圖;C) 抑制區(qū)統(tǒng)計(jì)圖;D) 抑菌率。
圖3 CS/CA/Ag冷凍凝膠的血液相容性和止血能力。A) 血細(xì)胞粘附的SEM圖像;B)凝固過程代表性照片;C) BCI;D)血液吸收率;E)大鼠肝臟切口模型;F)失血;G)對(duì)照組、明膠海綿、止血部位應(yīng)用CS/CA/Ag2冷凍凝膠的代表圖片;H)大鼠肝損傷模型;I)失血;J)對(duì)照組、明膠海綿、止血部位應(yīng)用CS/CA/Ag2冷凍凝膠的代表圖片。
圖4 CS/CA/Ag冷凍凝膠體內(nèi)感染全層創(chuàng)面愈合及生物安全性研究。A) 分別在第0、7、10天對(duì)感染金黃色葡萄球菌的傷口拍照;B) 不同愈合時(shí)間的傷口愈合模擬;C) 不同愈合時(shí)間的創(chuàng)面閉合率;D) 在第7天和第10天用不同低溫處理的再生皮膚組織切片進(jìn)行H&E染色;E) 創(chuàng)傷后第0天和第14天,用CS/CA/Ag2冷凍凝膠處理主要器官組織切片進(jìn)行H&E染色;F) 大鼠植入CS和CS/CA/Ag2冷凍凝膠第7天和第21天組織切片的H&E染色。
上述成果以“Shape memory and antibacterial chitosan-based cryogel with hemostasis and skin wound repair”為題,在線發(fā)表于《Carbohydrate Polymers》上。文章第一作者是山東大學(xué)博士研究生曹淑君,通訊作者是陳景帝教授。
